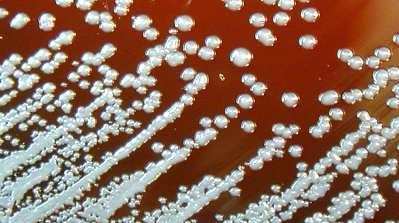

培养于血液琼脂板上的类鼻疽杆菌
你可能从来没有听过这种传染病,即使它在2015年造成了大约90000人的死亡,相当于麻疹的严重程度。它可能在传播10年以后才会在宿主体内显现,而且发病特征多种多样:可以像脓疮、发热、头疼,肺部感染造成的咳嗽以及胸口疼痛等等,因此极易与结核病混淆。
这类脓疮一样的疾病叫做类鼻疽。最近一个研究团队发表了这类疾病的全球流行趋势以及造成的死亡人数。“很高兴看到这样的文章发表”,特克萨斯州医科大学的微生物学家Alfredo Torres说到。“很显然,这类疾病已经被我们所认知,而今后也应当花更多精力在上面”。
类鼻疽是由一类叫做类鼻疽杆菌造成的。这类细菌通常生活在土壤中,人类与许多动物能够通过皮肤或引用带有传染源的水受到感染。这类微生物能够造成急性反应,或者潜伏体内长达十几年之久,直到类鼻疽爆发。因此,这一疾病有一个外号“越南定时炸弹”。类鼻疽杆菌对多种抗生素都有较强耐受性,一旦感染,一半的患者都将死亡。
为了预测该疾病真正的全球流行趋势,来自泰国曼谷的研究者Direk Limmathurotsakul等人建立了一个模型,将地球划分为8百万个5平方公里的小块。通过土壤鉴定数据,温度,降雨,以及过去100年来22000例人与动物感染的病例。他们计算出每块土地中类鼻疽杆菌的数量。通过泰国境内已知的地方疾病数据,他们估计了类鼻疽的感染程度。该模型表明,这类疾病在热带国家最为常见。有34个国家经鉴定包括在内,即使之前从没有相关的报道。该结果发表在最近一期的《nature microbiology》杂志上。他们估计2015年的感染病例为165000,其中包括89000人因此死亡。
“这项研究十分重要”,来自贝勒医学院国家热带医学研究院的院长Peter Hotez说到。“它描述了该疾病在全球范围内的高致死率,是一类不能忽视的热带疾病”。然而,不知为何该疾病却没有受到各方的重视。这篇文章将会打开那些参与公共健康政策制定者的眼界。







